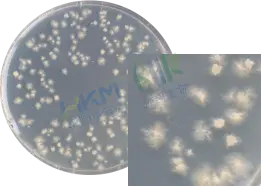
置厌氧条件下培养 48～72 小时，菌落直径2-6mm，中部凸起，白色到淡黄色，具有灰色，假根状、半透明，表面无光泽

生孢梭菌 CMCC(B)64941 菌种确认解决方案
发布时间:2026-01-04 浏览次数:458 分享:

随着2025版《中国药典》的颁布和实施,对制药企业微生物检验人员的技术能力提出更高要求,且菌种确认和鉴定也成为了大家极为关注的焦点。
因此,环凯依据《中国药品检验标准操作规范》、2025版《中国药典》四部通则9204 微生物鉴定指导原则和《伯杰氏系统细菌学手册》现行版,给大家提供菌种确认的整体解决方案。
生孢梭菌CMCC(B)64941菌种确认试剂(参考伯杰氏手册、参考2019中国药品检验操作规范)
产品名称 | 货号/ 规格 | 备注 | 生孢梭菌的特征 | ||
哥伦比亚琼脂培养基 | 024064 250g,干粉 | 用于生孢梭菌纯度和菌落特征确认。 | 置厌氧条件下培养 48~72 小时,菌落直径2-6mm,中部凸起,白色到淡黄色,具有灰色,假根状、半透明,表面无光泽。 ![]() | ||
哥伦比亚琼脂培养基(中国药典)-环凯微生物官网 /show/20651.html | |||||
革兰氏染色液(孢子次端生) | 029010 10ml×4瓶 | 用于显微形态确认。 | 革兰阳性梭菌,有或无卵圆形或球形的芽孢 | ||
革兰氏染色液-环凯微生物官网 /show/21027.html | |||||
3%过氧化氢溶液 | 029161 10支/盒 | 用于触酶试验。 | 触酶阴性,无气泡产生 | ||
3%过氧化氢溶液(过氧化氢酶试验试剂)-环凯微生物官网 /show/20985.html | |||||
乳糖明胶 | 075850 20支/盒 | 用于明胶和乳糖利用特性确认。 | 不利用乳糖,培养基不变色;明胶液化 | ||
乳糖明胶生化鉴定管-环凯微生物官网 /show/20840.html | |||||
结论:标准菌株CMCC(B)64941经上述试验确认符合生孢梭菌的特性。